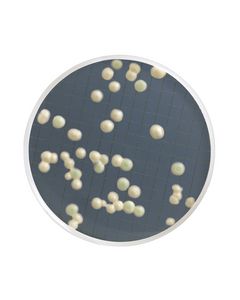
MHA00P2SM.jpg

The store will not work correctly when cookies are disabled.
- Termos de pesquisa relacionados
-
millipore
-
FILTRAÇÃO POLISULFONA NALGENE/47MM
-
FILTRAÇÃO POLISULFONA
-
filtracao polissulfona nalgene 47mm
-
filtracao polissulfon nalgene 47mm

ANEL DE ALUMINIO PARA TRAVA SISTEMA HIDROSOL (UND) MILLIPORE
Modelo: XX2004701
R$ 1.281,10

JUNTA DE TEFLON PARA TELA SWINNY MILLIPORE - 10 UND
Modelo: XX3001202
R$ 531,55

KIT PEÇAS REPOSICAO PARA SUPORTE 47 MM MILLIPORE - UND
Modelo: XX40047RK
R$ 3.121,85

FRASCO PLASTICO DISPENSADOR DE SOLVENTES EM PE 50ml MILLIPORE
Modelo: XX6504704
R$ 389,95

CONEXAO RAPIDA 1/4 EM ACO INOX MILLIPORE - UND
Modelo: XX6700030
R$ 1.174,64

PLUGUE EM INOX 1/4" NPT MILLIPORE - 02 UND
Modelo: YY1301009
R$ 374,22

HOLDER DIAM 90 mm EM AÇO INOX MILLIPORE - UND
Modelo: YY3009000
R$ 11.472,63

MEIO SORO DE LARANJA EM AMPOLA 2ml (CX) MILLIPORE
Modelo: MHA000P20
R$ 1.455,59

M ENDO BROTH DESIDRATADO MILLIPORE EMB C/ 100 GR
Modelo: MB000000E
R$ 1.456,66

MEIO SELETIVO PARA LEVEDURAS EM AMPOLA 2ml (CX) MILLIPORE
Modelo: MHA00P2SM
R$ 955,86

TAMPAO RINSAGEM STERITEST FLUIDO K USP 300ml ESTERIL MILLIPORE
Modelo: STBMRFK34
R$ 516,74

STERITEST DISPOSITIVO PARA VENTILACAO FRASCO MEMB. FG (CX) MILLIPORE
Modelo: TEFG02525
R$ 2.967,28